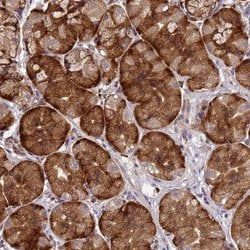
Img

MINT3 Polyclonal Antibody, Invitrogen™
Manufacturer: Thermo Scientific
Select a Size
| Pack Size | SKU | Availability | Price |
|---|---|---|---|
| Each of 1 | PIPA561037-Each-of-1 | In Stock | ₹ 49,439.50 |
PIPA561037 - Each of 1
In Stock
Quantity
1
Base Price: ₹ 49,439.50
GST (18%): ₹ 8,899.11
Total Price: ₹ 58,338.61
Antigen
MINT3
Classification
Polyclonal
Conjugate
Unconjugated
Gene
APBA3
Gene Alias
Adapter protein X11gamma, amyloid beta (A4) precursor protein-binding family A member 3 (X11-like 2), amyloid beta (A4) precursor protein-binding, family A, member 3 (X11-like 2), amyloid beta (A4) precursor protein-binding, family A, member 3, amyloid beta (A4) precursor protein-binding, family A, member 3 (X11-like 2), amyloid beta A4 precursor protein-binding family A member 3, amyloid beta precursor protein binding family A member 3, Amyloid-beta A4 precursor protein-binding family A member 3, Apba3, AW208791, lin 10, lin-10, MGC:15815, Mint 3, MINT3, mint-3, Neuronal Munc18-1-interacting protein 3, neuron-specific X11L2 protein, phosphotyrosine-binding/-interacting domain (PTB)-bearing protein, X11gamma, X11L2, X11-like 2 protein
Host Species
Rabbit
Purification Method
Antigen affinity chromatography
Regulatory Status
RUO
Gene ID (Entrez)
9546
Content And Storage
Store at 4°C short term. For long term storage, store at -20°C, avoiding freeze/thaw cycles.
Form
Liquid
Applications
Immunohistochemistry
Concentration
0.5 mg/mL
Formulation
PBS with 40% glycerol and 0.02% sodium azide; pH 7.2
Gene Accession No.
O96018
Gene Symbols
APBA3
Immunogen
Recombinant protein corresponding to Human MINT3
Quantity
100 μL
Primary or Secondary
Primary
Target Species
Human
Product Type
Antibody
Isotype
IgG
Description
- Immunogen sequence: QFEALPGDLV GPSPGGAPCP LHIATGHGLA SQEIADAHGL LSAEAGRDDL LGLLHCEECP PSQTGPEEPL EPAPRLLQP Highest antigen sequence identity to the following orthologs: Mouse - 70%, Rat - 68%
- The munc-18 interacting protein (Mint) protein family is a group of evolutionarily conserved adaptor proteins that function in membrane transport and organization
- In mammals, there exist three mint isoforms, Mint1, 2, and 3
- Although there is little amino acid sequence conservation in the amino-terminal half, the carboxy-terminal half of these proteins is highly conserved
- Within this conserved portion there exists a phosphotyrosine-binding (PTB) and a PSD-95/DLG-A/ZO-1 (PDZ) domain, which function as protein interaction modules
- Mint1 and 2 appear to be expressed exclusively in the brain and are found to bind to Munc18, an essential component of the synaptic vesicle fusion machinery
- Mint3 is ubiquitously expressed in all tissues and is expressed at the lowest levels in the brain and testis
- Studies show that mint3 does not interact with munc-18
- Mint3 has been found to interact with the Alzheimer's Disease-related amyloid precursor protein (APP) and does so through its PTB and PDZ domains
- It has been suggested that mint3 links APP to other transport machinery components, thereby regulating it transport, endocytosis, and metabolism
- Abnormal APP metabolism has been shown to be the cause of an early-onset type of Alzheimer's disease.